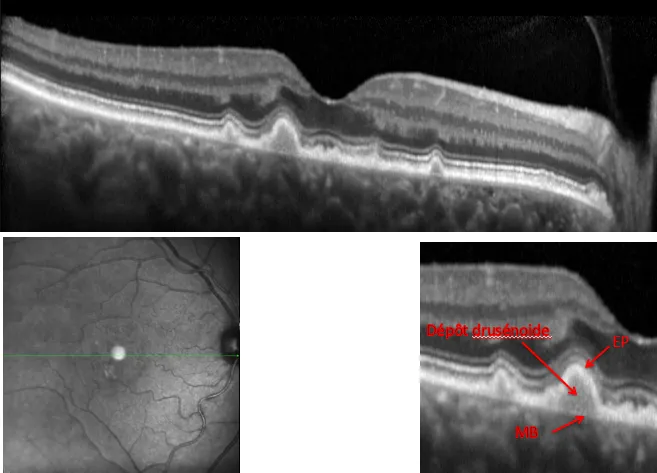
3
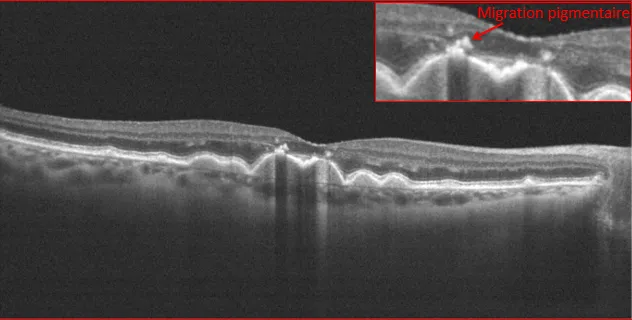
3
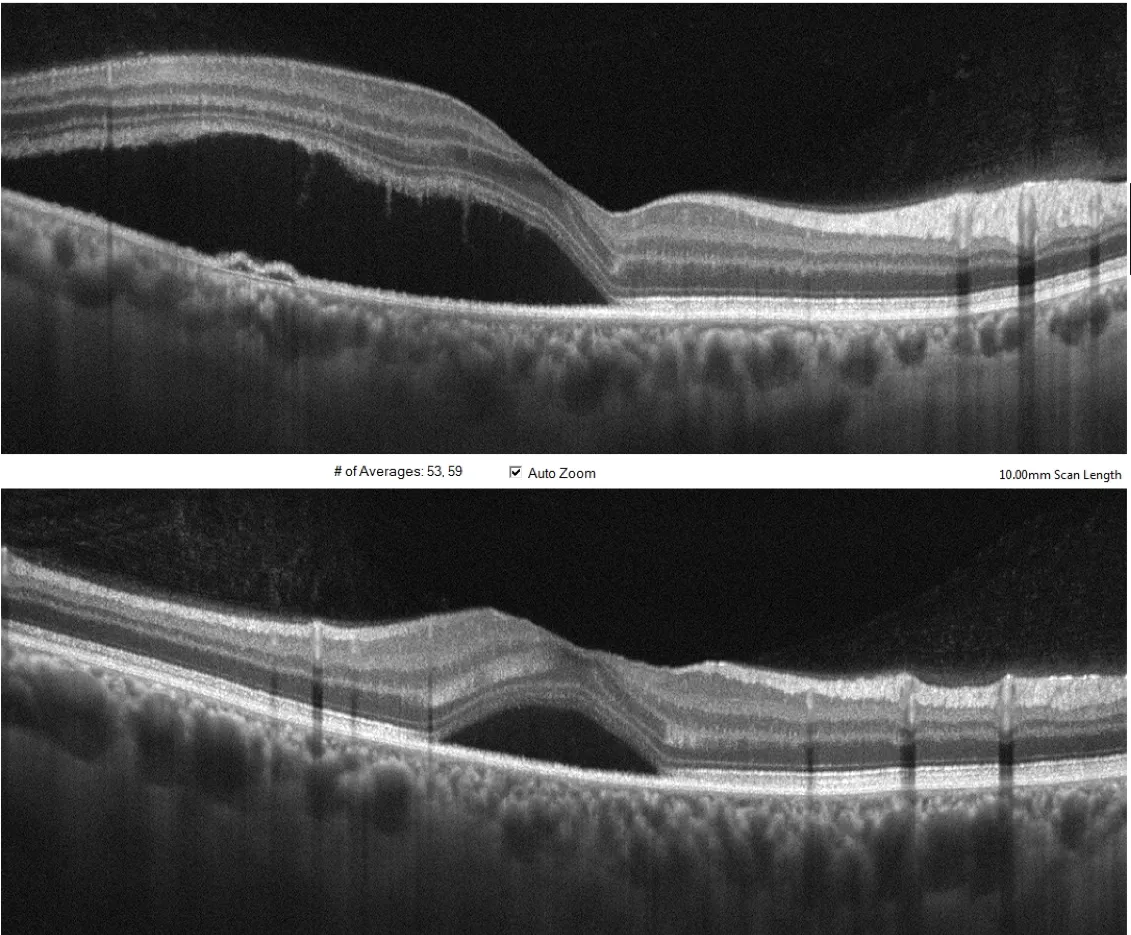
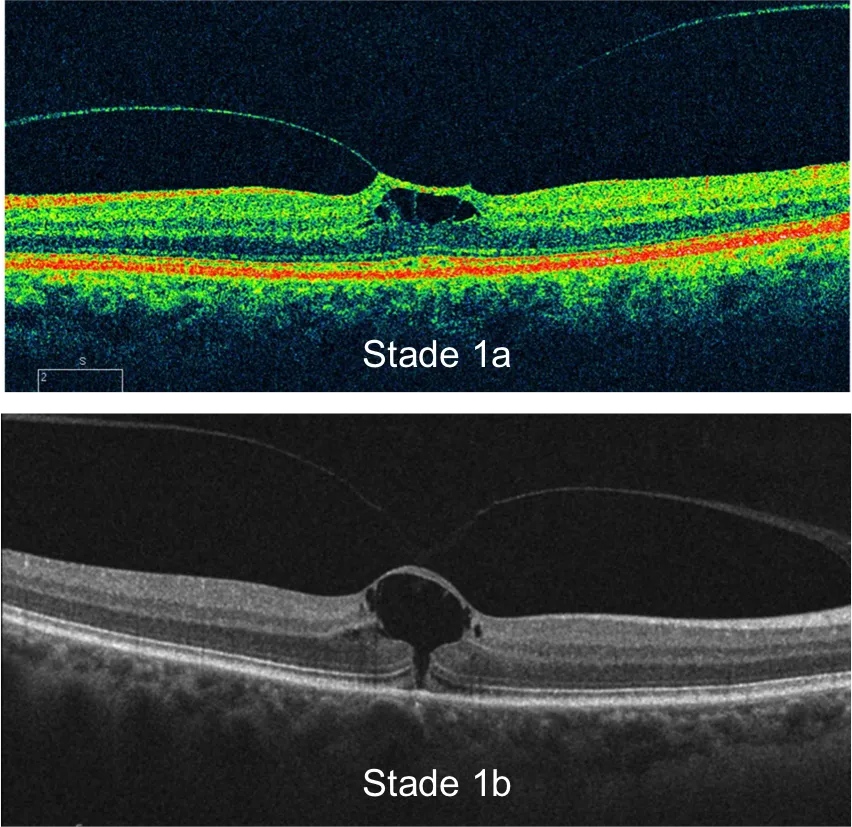
trou mac deb
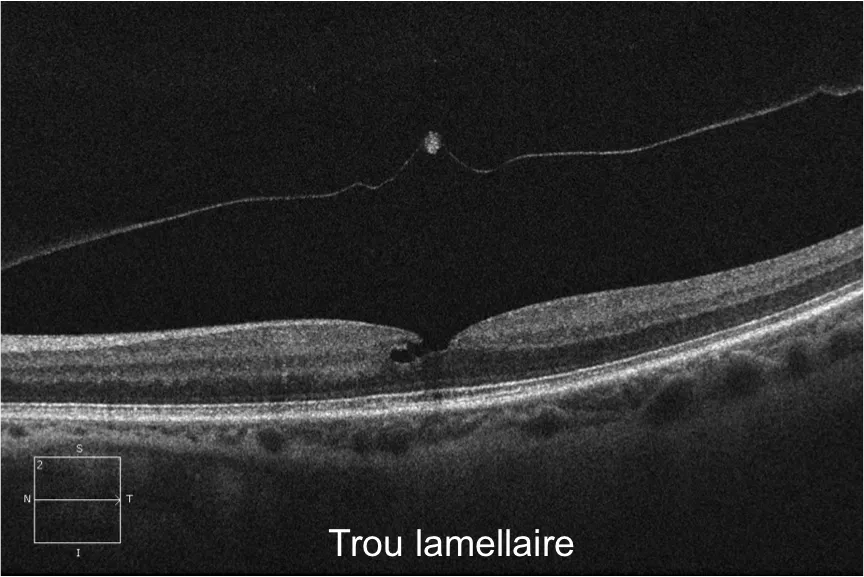
trou lamellaire

Pathologies Oculaires
Le centre Ophtalmologique Rabelais prend en charge les différentes pathologies de la rétine dont le diagnostic fait appel à de nombreux examens spécifiques permettant d'orienter le traitement.
L’ŒIL NORMAL :

1. La Cornée

• La cornée est un tissu transparent ,avasculaire , constituant la première vitre de l'oeil c'est à dire la partie la plus antérieure du globe oculaire .
• La cornée est une lame à face parallèle avec des rayons de courbures qui sont propres à chaque individu .
• La cornée est constituée de 6 couches :
• Le film lacrymal
• l'épithélium cornéen
• la membrane de Bowman
• le stroma cornéen
• la membrane de descemet
• l'endothélium cornéen
Une perte de la transparence de la cornée peut entrainer une baisse d'acuité visuelle proportionnelle au degré d'atteinte.
2.L’iris

• L'iris est une membrane circulaire constituant la partie colorée visible de l'oeil .
• L'iris joue un rôle de diaphragme , réflexe physiologique modifiant son diamètre afin de réguler l'entrée de la lumière dans l'oeil . On parle alors de myosis quand le sphincter irien se rétracte et de mydriase lorsque la pupille est dilatée .
3.Cristallin

• Le cristallin est une lentille naturelle transparente ,biconvexe, ayant la capacité de se déformer pour permettre un mécanisme fondamental de la vision qu'est l'accommodation .
• Il est situé en arrière de l'iris et est maintenu en place par des ligaments appelés zonule reliée au muscle ciliaire.
• Cette déformation du cristallin est rendue possible grâce au muscle ciliaire qui, lorsqu'il se contracte, va agir par l'intermédiaire de la zonule sur le cristallin.Cette modification morphologique va induire un changement de focale permettant de passer de la vision de loin à la vision de près avec une sorte de focus de l'image .
•Avec l'âge , le cristallin se durcit et perd sa souplesse progressivement conduisant à la presbytie à partir de 40ans avec pour conséquence des difficultés de mise au point en vision de près ,nécessitant une correction optique de près .
• Au cours du vieillissement , le cristallin va s'opacifier de manière partielle ou totale induisant une baisse progressive de la vision
4.Le vitré

•Le vitré est une substance de consistance gélatineuse remplissant une partie de la cavité oculaire entre la face postérieure du cristallin et la rétine , garantissant le volume de l'oeil .
•Le vitré est d'aspect transparent et complètement avasculaire .
5. La rétine

•La rétine est une fine membrane constituant la face interne de l’oeil . Les différentes cellules visuelles contenues dans la rétine vont réceptionner l’information visuelle et la transformer en influx nerveux .Ce message visuel est ensuite véhiculé par le nerf optique vers le cerveau pour en interpréter les images.
•La rétine est en contact par sa face postérieure, avec un réseau très vascularisé appelé la choroïde. L’interface entre la rétine et la choroïde est représentée par la couche la plus profonde de la rétine qu’on appelle l’épithélium pigmentaire.
6.Le nerf optique
•Le nerf optique est tout un segment reliant la rétine au cerveau permettant la transmission de l'information visuelle . La lumière va être transformée en influx nerveux puis véhiculée par l'intermédiaire des fibres optiques du nerf au cerveau .
•Les deux nerfs optiques se rejoignent au niveau du chiasma dans le cerveau .
•Lors de l'examen clinique du fond d'oeil ,on ne visualise que la partie antérieur du nerf optique que l'on appelle la papille . Son trajet rétro équatorial peut être visualisé grâce à l'imagerie radiologique.

LA DMLA :
1.MLA: Maculopathie Liée à l’âge( Stade prémice de la DMLA)
• C'est le stade précurseur de la DMLA qui se caractérise par l'apparition de fins dépôts amorphes dans la rétine aux deux yeux, appelés "Drusen", pouvant s'associer à quelques anomalies de la pigmentation rétinienne.
• A ce stade , aucun symptôme n'est perceptible . Seul un examen du fond d'oeil réalisé par votre ophtalmologiste permet de dépister ces altérations de la rétine .

2.DMLA:Drusen Séreux
• Les dépots dans la rétine sont plus nombreux et de plus grandes tailles(Drusen séreux)
• Ces dépôt peuvent être confluents , coalescents et s'associer à des anomalies de la pigmentation rétinienne
• A ce stade , des légères déformations des lignes droites peuvent être perçues associées à des variations de la vision en fonction de la luminosité .
• Un dépistage chez votre ophtalmologiste permettra d'adapter le suivi et d'intervenir de manière précoce en cas de complication vers une forme de DMLA "Humide"

3.DMLA: Coalescence des Drusen et DEP Drusénoïde

4.Evolution de la DMLA
A) DMLA Néovasculaire ou « Humide »
• Ce stade est caractérisé par l'apparition de vaisseaux anormaux appelés néovaisseaux choroïdiens dans ou sous la rétine
• La présence de ces néovaisseaux s'accompagne très souvent de la présence d'hémorragie au fond d'oeil et de fluide , d'oedème intrarétinien responsable d' une baisse d'acuité visuelle.
• Une prise en charge thérapeutique par l'intermédiaire d'injection d'un médicament dans la cavité intra-vitréenne permettra de réduire la croissance de ces néovaisseaux et de résorber les signes indirects de l'activité de ces vaisseaux que sont l'oedème et le fluide intra-rétinien.
• L'importance d'un traitement précoce permettra une meilleure conservation de l'acuité visuelle.
• Un examen de l'oeil non atteint est indispensable car la prévalence de décompensation de cet oeil augmente lorsque un oeil est déjà atteint :
• Taux de bilatéralisation de 20% à 90% à 5 ANS selon le type de Néovaisseaux
B) DMLA Atrophique ou « sèche »

• Les dépôts rétiniens appelés "Drusen" vont se calcifier secondairement laissant place à une atrophie des photorécepteurs et de l'épithélium pigmentaire ,couches les plus profondes de la rétine , conduisant à une atrophie de la rétine localisée appelée: Atrophie Géographique .
- • En règle générale , son évolution est lente et progressive avec une extension des plages atrophiques .
- • Il n'existe pas de traitement pour cette forme de la maladie mais un suivi est fortement recommandé car elle peut se compliquer secondairement de Néovaisseaux et présenter une composante dite "Humide".
- • Récemment , des nouvelles molécules pharmacologique sont en cours d'évaluation dans le cadre d'études cliniques , au sein du centre Rabelais, avec pour objectif premier de ralentir l'évolution de la maladie .(cf menu études cliniques )
Myopie forte
• Une myopie est considérée comme forte lorsqu’elle dépasse une correction optique de -6 Dioptries et peut parfois être appelée myopie dégénérative lorsque l’œil continue à grandir à l’âge adulte.
• La myopie peut avoir une corrélation biométrique avec en général un œil plus long, dépassant la longueur moyenne du globe de 24 millimètres.
• L’allongement du globe oculaire a comme conséquence un amincissement de la rétine et ses annexes (Choroïde) induisant une certaine fragilisation oculaire avec une prévalence plus importante de développer une cataracte, un glaucome, des maculopathies (membrane épi-rétinienne, trou maculaire, fovéo schisis) et un décollement de rétine.
• C’est pour cela qu’il est recommandé de réaliser un examen du Fond œil chez les myopes forts au minimum une fois tous les 2 ans.

• Une des complications les plus fréquentes est la prolifération de vaisseaux anormaux sous la rétine, appelés Néovaisseaux, provoquant des symptômes tel que des déformations des lignes droites associées ou non à une baisse d’acuité visuelle.
• On peut comparer les Néovaisseaux du myope fort à ceux survenant dans la DMLA mais ces maladies restent complètement distinctes. Il est d’ailleurs possible de développer ce genre de complications chez le myope fort avant l’âge de 50 ans (âge moyen de survenue d’une DMLA)
• Traitement : Le traitement des néovaisseaux consiste à réaliser des injections intra oculaires d’anti-VEGF qui vont bloquer les facteurs de croissance de ces vaisseaux anormaux et en réduire les phénomènes oedémateux associés.
Rétinopathie Diabétique
•Prévalence du diabète en France et en Outre Mer en 2009.
•2,7 millions de personnes sont traitées pour leur diabète (6% de la population)
Le diabète de type 2, non insulino-dépendant, représente le 92% de tous les diabètes.
La prévalence maximale pour développer un diabète se situe dans la tranche d’âge 75-79 ans.
La prévalence continue à augmenter (+ 4.7%/an entre 2000 et 2009) en raison de l’augmentation de l’espérance de vie, du vieillissement, de la prévalence de l’obésité et de l’intensification du dépistage.
•Les complications vasculaires.
Le diabète induit des nombreuses complications MACRO et MICRO vasculaires. Le coeur, le cerveau, les reins , le système nerveux périphérique ainsi que la rétine peuvent donc être affectés par cette maladie.
Au niveau du fond de l’oeil, le diabète peut affecter la périphérie rétinienne mais aussi la région centrale de la rétine appelée la macula. Les modifications micro-vasculaires de la région maculaire peuvent induire une rupture de la barrière hémato-rétinienne à l’origine de la formation d’un œdème dans la rétine et pouvant être responsables d’une baisse de l’acuité visuelle.
On parle alors d’oedème maculaire diabétique (OMD). La rétinopathie diabétique est la première cause de cécité dans la population active et, en 2002, l’OMS estimait que 5% de cas de cécité dans le monde sont liés à la RD. La cécité dépend souvent de l’ancienneté du diabète. On estime qu’après 15ans de diabète, 2% des patients sont aveugles et 15% malvoyants.
•Date du premier bilan ophtalmologique nécessaire au diagnostic du diabète.
•Difficultés d’établir l’ancienneté du diabète (premier facteur de risque de la RD):
- Un premier examen ophtalmologique (Acuité visuelle, examen du Fond d'oeil en mydriase) est nécessaire dans ces situations :
- Chez l’adulte : Au diagnostic de diabète de type 2, ou lorsque la forme nosologique n’est pas certaine .
•3 ans après le diagnostic de diabète de type 1 - Chez l’enfant:
- •À partir de 10 ans
Le contrôle de l’équilibre glycémique et celui de la pression artérielle sont des mesures de prévention primaire de la rétinopathie diabétique .
Equilibration des facteurs de risque reste l’élément fondamental pour lutter contre la Rétinopathie diabétique.
•D’après les recommandations de l’HAS 2010.
•Dépistage annuel:
•Recommandé chez la quasi totalité des patients diabétiques
•Dépistage tous les 2 ans
•Patients non insulino-traités sans Rétinopathie Diabétique
•Equilibrés pour l’hémoglobine glyquée (HbA1c)
•Equilibrés pour la tension artérielle
•Femmes enceintes:
•Dépistage avant la grossesse, puis trimestriel, puis en post-partum
•Rétinopathie diabétique : les moyens diagnostiques.
•Examen à la lampe à fente et photographies couleur du fond du fond d’œil•
•Angiographie à la fluorescéine (conseillée au diagnostic du diabète)

Angiographie à la fluorescéine :Oedème Maculaire du Diabétique (OMD). Epaississement ou gonflement de la rétine dû à la fuite de fluide à partir des vaisseaux sanguins de la macula.L’OMD provoque une vision trouble par bouleversements du fonctionnement de la rétine.
•Tomographie en cohérence optique (OCT):
Tomographie à cohérence optique(OCT) d'un oedème maculaire Diabétique montrant un épaississement de la région maculaire . L'OCT , au delà de son apport diagnostique , permettra d'apprécier l'évolution de cet oedème .
•Angiographie OCT(OCT-A)
Occlusion Vasculaire
En Cours de redaction..
Maladie de Coats
•Epidémiologie
L'incidence annuelle est < 1/1 000 000 au Royaume-Uni. Environ 80% des cas surviennent chez les garçons.
•Description clinique
La maladie de Coats survient majoritairement chez des garçons âgés entre 6 et 8 ans. Les stades précoces de la maladie sont généralement asymptomatiques et l'évolution est variable. De manière générale , les enfants souffrant d'une perte de vision unilatérale ne s'en plaignent pas et le diagnostic est souvent suspecté face à l'aspect anormal du reflet pupillaire qui peut être mieux observé sur des photos ou par recherche du reflet rétinien. D'autres manifestations fréquentes incluent l'apparition d'un strabisme ou un échec lors des examens visuels de routine en milieu scolaire. L'ophtalmoscopie révèle une télangiectasie rétinienne unilatérale et des anévrismes des vaisseaux rétiniens, suivis par des exsudats produisant de dépôts jaunes sous-rétiniens. Les stades les plus avancés de la maladie de Coats incluent un décollement total de la rétine, une leucocorie et un glaucome douloureux à angle fermé.
•Etiologie
Une perméabilité anormale des cellules endothéliales capillaires de la rétine et des péricytes anormaux sont responsables de la fuite vasculaire rétinienne qui est la principale caractéristique de la maladie. La maladie de Coats n'est pas héréditaire, cependant des mutations du gène « Norrie Disease Pseudoglioma » NDP pourraient jouer un rôle dans la pathogénèse de la maladie.
•Méthode(s) diagnostique(s)
Les explorations diagnostiques incluent l'ophtalmoscopie directe ou indirecte (examen du fond de l’œil en dilation), l'angiographie à la fluorescéine, l'échographie, la tomodensitométrie (OCT) et l'imagerie par résonance magnétique (IRM).

Montage de clichés du Fond d'oeil couleurs montrant quelques dilatations vasculaires visibles en supéro temporal chez un jeune homme de 17 ans dans le cadre d'une maladie de Coats .

Examen d'OCT-Angiographie du même patient permettant d'imager le flux intravasculaire et mettant en évidence de nombreuses dilatations des capillaires intra-rétinien dans la région temporo-fovéolaire dans le cadre d'une maladie de Coats
•Diagnostic(s) différentiel(s):
Le rétinoblastome (tumeur de la retine) est le diagnostic différentiel le plus important. L'échographie en mode B et l'IRM par gadolinium permet de faite la distinction entre le stade tardif de la maladie de Coats et une tumeur solide.
Les autres diagnostics différentiels incluent la vitréo-rétinopathie exsudative familiale, la maladie de von-Hippel-Lindau, l'uvéite intermédiaire et l'incontinentia pigmenti qui sont le plus souvent bilatérales, ainsi que les pathologies typiquement unilatérales, telles que la toxocarose oculaire et la persistance du vitré primitif.
•Prise en charge et traitement :
Le traitement dépend de la sévérité de la maladie. Les anomalies vasculaires périphériques légères peuvent être suivies par une série de photographies du fond de l'oeil. En cas d'exsudation, le traitement des dilatations vasculaires et de la rétine périphérique ischémique (non perfusée) repose sur la photocoagulation au laser. En cas d’exsudation maculaire, un traitement par injections intra-vitréennes d’anti-VEGF pourra être proposé. Les cas les plus avancés peuvent nécessiter une intervention chirurgicale pour la ré-application de la rétine, telle que l'indentation sclérale ou la photocoagulation laser combinée à la vitrectomie.
•Pronostic :
La plupart des cas se stabilisent avec une thérapie appropriée, bien que l'exsudation et les cicatrices maculaires altèrent fréquemment la vision. Si une grande majorité des formes de l’adulte peut être efficacement traitée avec une acuité visuelle résiduelle d’environs 5/10, les formes négligées ou méconnues de l’infant aboutissent à la cécité légale et parfois à l’énucléation.
CRSC (Chorio-Rétinopathie -Séreuse-Centrale)
La CRSC est une affection chorio-rétinienne caractérisée par des soulèvements exsudatifs de la rétine.
Différentes incidences de coupe 2D par imagerie OCT de la région maculaire d'un patient présentant une bulle de DSR(Décollement séreux rétinien)
•La CRSC, bien reconnue au début des symptômes fonctionnels, est une affection normalement bénigne qui peut être souvent récidivante avec une tendance à la bi- latéralisation.
Les décollements séreux de la CRSC, qu’il ne faut pas confondre avec les décollements de rétine reghmatogènes, sont dus à l’apparition de points de fuites qui seraient liés à une hyperperméabilité, un épaississement et à une modification structurelle du réseau vasculaire profond sous la rétine qu ‘on appelle la choroïde . Cette entité rentre dans le spectre de maladie dénommé « Pachychoroïde ».

Troncs choroïdien dilatés dans le cadre d'une Pachychoroïde
- •Symptômes. : Baisse de vision plus ou moins associé à des déformations des lignes droites (métamorphopsies).
- •Evolution :
Le 2/3 des poussées de CRSC sont spontanément résolutives et sans séquelles visuelles. Dans 1/3 des cas, le décollement séreux devient chronique avec des altérations rétiniennes irréversibles empêchant une récupération de la vision.
- •Diagnostic :
Le diagnostic initial est établi grâce à l’imagerie tomographique appelée OCT (tomographie en cohérence optique).
Cet examen met en évidence le soulèvement rétinien localisé ainsi que l’épaississement de la choroïde sous-jacente. L’OCT permet également de détecter d’autres pathologies secondaires à la CRSC comme les néovaisseaux occultes sur pachychoroïde ou la vasculopathie polypoïdale choroïdienne. La détection précoce de ces affections permet souvent d’éviter des complications sévères avec parfois des pertes irréversibles de l’acuité visuelle.
L’angiographie à la fluorescéine est réservée au cas de CRSC chroniques dans la perspective d’un traitement.
L’angiographie au vert d’indocyanine sera réalisée seulement dans des cas sévères où l’angiographie à la fluorescéine n’a pas élucidé la conduite à tenir, ou en cas de soupçon de formes plus complexes de pathologies liées au spectre de maladie de la pachychoroïde.
Plus récemment, l’OCT-Angiographie semble dans certain cas remplacer l’angiographie à la fluorescéine.
-
•Traitement :
Un traitement dans le cadre de la CRSC peut être proposé à partir d’une période d’observation d’au moins 6 mois d’évolution de l’exsudation, ou de 3 mois en cas de formes récidivantes.
Le but du traitement est d’occlure les points de fuite pour permettre à la rétine sensorielle de se réappliquer sans séquelle fonctionnelle. `
Le traitement de la CRSC repose classiquement sur la photocoagulation au laser des points de fuite.
Ce traitement ,laissant une cicatrice au site du point de fuite , ne peut pas être proposé si le point de diffusion est localisé à proximité de la fovéa (distance minimale requise : 200 micron du point centrale de la macula).
En cas de points de fuites multiples ou trop proches de la fovéa, un traitement par photothérapie la Visudyne(PDT) peut être proposé. Le principe sous-jacent à l’occlusion des points de fuite suite à la PDT n’est pas complétement élucidé.
On pense cependant que la PDT agirait sur la vascularisation choroïdienne en induisant un remodelage des vaisseaux choroïdiens, suivi d’une diminution de l’hyper perfusion profonde et d’une diminution à terme de l’épaisseur choroïdienne.
L’association thérapeutique(Bi-Thérapie) de la PDT aux injections intra-vitréenne d’anti-VEGF est réservée au cas de CRSC sur Pachychoroïde compliqués par des néovaisseaux choroïdiens.
Image d'OCT-ANGIOGRAPHIE d'une CRSC compliquée de Néovaisseaux Choroïdien
Chronic central serous chorioretinopathy imaged by optical coherence tomographic angiography.
Quaranta-El Maftouhi M, El Maftouhi A, Eandi CM.
Am J Ophthalmol. 2015 Sep;160(3):581-587.e1. doi: 10.1016/j.ajo.2015.06.016. Epub 2015 Jun 29
Maladie de Best
•La maladie de Best est une dystrophie maculaire génétique bilatérale, encore appelée dystrophie vitelliforme juvénile, qui entraîne une baisse tardive de la vision.
Cette maladie est autosomique dominante de pénétrance variable. On note une grande variabilité phénotypique.
Le gène VMD2 (Vitelliform Macular Dystrophy) a été localisé en 11q13
•La maladie est découverte en général par hasard chez des enfants ou à l'occasion d'un bilan familial. On est souvent étonné de la discordance qu'il y a entre le peu de signes fonctionnels et l'importance des lésions anatomiques.
Il s'agit aussi parfois d'adultes qui se plaignent d'une baisse d'acuité visuelle. L'examen met en évidence une tâche jaune au niveau de la macula, avec un aspect de "jaune d'oeuf sur le plat" (egg-yolk). Les deux yeux peuvent présenter des lésions différentes.
Ceci correspond à l'accumulation de matériel de lipofuschine au sein de l'épithélium pigmentaire(EP) et en dessous de cet EP. Il semble que l'anomalie touche d'abord l'épithélium pigmentaire avant d'altérer les photorécepteurs.
Il existe des formes à disques vitelliformes multiples disséminés au pôle postérieur.
L'aspect typique de l'électro-oculogramme (EOG) avec un rapport d'Arden inférieur à 1,5 fait le diagnostic.
L'EOG peut être anormal alors qu'aucune lésion rétinienne n'est encore apparue.
Lors de l'angiographie on note d'abord une auto-fluorescence du disque, qui va apparaître sombre après l'injection, avec une légère imprégnation aux temps tardifs. L'ERG est normal et la vision des couleurs montre une anomalie de type dyschromatopsie d'axe bleu-jaune.
•Stades de la maladie
1) Au stade prévitelliforme, on observe aucune lésion rétinienne et la vision est conservée.
2) Au stade de disque vitelliforme, l'acuité visuelle diminue souvent un peu.
3) Après cette phase vitelliforme typique, on assiste à une modification de ce matériel avec une phase fragmentation ou sédimentation de ce dernier avec apparition d'un aspect dit en "oeuf brouillé". La vision baisse nettement à ce moment.
4) Les éléments de la formation vont alors sédimenter et donner une image de pseudo-hypopion par gravitation avec espace optiquement vide .
5) L'atrophie de la région maculaire termine l'évolution, qui peut parfois se compliquer de néovascularisation sous-rétinienne, avec scotome central majeur d’ou l’importance d’un suivi régulier
.•Traitement :
Il n’existe pas de traitement à cette maladie au sens strict du terme cependant lorsque une complication néovasculaire survient , elle peut bénéficier d’un traitement par injection intravitréenne pour créer une vasconstriction de cette membrane néovasculaire .
Lorsque l’atteinte visuel est significative , des aides optiques vous seront préconisées pour améliorer votre vision .
Rétinite Pigmentaire
En Cours de redaction..
Décollement Postérieur du Vitré
•Au cours du vieillissement , souvent après 60 ans , le vitré va se liquéfier et l'on va observer un phénomène tout à fait physiologique qu'on appelle un décollement postérieur du vitré . Le vitré va se détacher progressivement de la paroi rétinienne avec un aspect de rétraction de l'enveloppe vitréenne .
•Des symptômes tels que des éclairs intermittents ou une sensation de toiles d'araignée peuvent être en rapport avec l'existence d'un début de décollement postérieur du vitré .
•En règle général , un contrôle du fond d'oeil permet de s'assurer de l'absence d'adhérence pathologique telle qu'une traction du vitré sur la rétine pouvant présenter un risque de décollement de rétine et du déroulement normal de ce processus physiologique .

Traction Vitréo-Maculaire
•Le syndrome de traction vitréo-maculaire idiopathique est un processus anormal de décollement du vitré. Il peut être suspecté à l'examen biomicroscopique dans les cas typiques assez évolués mais l'OCT permet de détecter des cas débutants non détectables à la lampe à fente.
•Sur les coupes OCT la membrane postérieure du vitré apparaît anormalement épaisse, et adhérente à la papille et à la macula. Elle est souvent connectée à une membrane épirétinienne qui adhère à la surface maculaire et consolide l'adhérence anormale du vitré à la rétine
•La traction peut entrainer un épaississement de la rétine ou un décollement des photorécepteurs

Déchirure Rétinienne à Clapet
Echographie en mode B avec mise en évidence d'une déchirure rétinienne
• En cas d'hémorragie dans la cavité vitréenne , la visualisation du fond d'oeil est perturbée voire impossible et nécessite le recours à l'échographie qui nous aidera à mettre en évidence la cause de l'hémorragie tel que dans ce cas vidéo où le siège de l'hémorragie était une déchirure rétinienne dit à clapet.
Décollement de Rétine
• Le décollement de Rétine est une urgence ophtalmologique indolore qui doit faire consulter rapidement un ophtalmologiste .
•Symptômes pouvant être évocateur d'un décollement de Rétine :
- Corps flottants qui se démultiplient et gêne votre champ visuel.
- Flash lumineux.
- Baisse d'acuité visuel.
- Rétrécissement du champ visuel.
- Sensation de voile noir ou de tâches.
•L'ensemble des symptômes visuels est bien représenté dans cette vidéo didactique ci dessus .
l
Trou Maculaire
•Les trous maculaires idiopathiques sont la conséquence d'un processus anormal de décollement du vitré qui reste exagérément adhérent au centre de la macula
•Avant même qu’une gène oculaire apparaisse, l'examen OCT peut montrer des minimes anomalies telle qu’une menace de trou maculaire (stade 1). Une cavité kystique se forme dans la partie la plus interne (superficielle) de la macula (figure 1a). A un stade plus avancé , le kyste maculaire, se prolonge en arrière par une rupture dans la couche des photorécepteurs (cellules visuelles) (figure1b) et latéralement en clivant rétine interne et rétine externe. La membrane postérieure du vitré reste attachée au sommet du kyste.
•Toutes les cavités kystiques ne sont pas des menaces de trou maculaire. Certaines sont dues à un œdème maculaire, d'autres à une dégénérescence tissulaire, mais l'association d'un kyste maculaire, d'une élévation du toit du kyste sous l'effet de la traction du vitré, sont évocateurs d'une menace de trou maculaire.
Le stade de trou constitué est appelé « Trou maculaire de pleine épaisseur ».
•Dans le stade 2, en OCT la membrane postérieur du vitré reste attachée à l'opercule lui même encore partiellement adhérent au bord du trou. La taille du trou de stade 2 est habituellement petite, inférieure à 300-400µm, mais elle peut être plus large notamment lorsque le trou de stade 2 dure depuis longtemps.
•Le stade 3 est un trou maculaire caractérisé par un décollement de la membrane postérieure du vitré en regard de la surface maculaire, contenant en général un opercule libre. Cette membrane vitréenne reste cependant attachée à la tête du nerf optique.
La rupture de cette attache vitréenne constitue le stade 4.

•Les trous maculaires lamellaires sont par définition une sorte de trous maculaires qui ne sont pas de pleine épaisseur. Ils sont la conséquence d’un décollement d'une lamelle de rétine interne (superficielle) de la macula avec la persistance de la rétine externe (profonde). L'amincissement rétinien modéré concerne surtout les couches internes.
•Trous maculaires opérés
L'OCT montre sans ambiguité si le trou est fermé ou non. Une petite rupture centrale cicatricielle des photorécepteurs persiste habituellement ce qui n'empêche pas l'amélioration visuelle si cette altération reste inférieur à 100 µm.
Membrane Epirétinienne (M.E.R)
•L'examen OCT permet de confirmer la présence d'une membrane épirétinienne suspectée à l’examen du fond d’œil. Il permet également de quantifier l'épaississement de la rétine centrale (secondaire à cette membrane) s’il y en a un. Depuis l'avènement de l'OCT, l'épaisseur de la macula fait partie des critères de décision pré-opératoire même si la relation entre l'acuité visuelle et l'épaississement maculaire est faible.

•Il faut rappeler que beaucoup de membranes n'entrainent pas d’épaississement maculaire significatif et qu’une membrane épirétinienne qui n'a pas entraîné une augmentation significative de l'épaisseur maculaire centrale n’est probablement pas responsable d'une baisse d’acuité visuelle (figure).

•Dans certains cas, on peut observer des cavités cystoïdes ou oedème dans l'épaisseur rétinienne. Une angiographie en fluorescence peut être indiquée dans ces cas pour vérifier l’origine de cet œdème maculaire et éliminer par exemple une DMLA associée.
•Pseudo-trous maculaires
•Le pseudo-trou maculaire est un aspect particulier du profil maculaire dû à la contraction d'une membrane épirétinienne avec verticalisation des bords de la pente de la depression maculaire. Il n’y a pas de rupture complète du tissu rétinien comme dans le trou maculaire de pleine épaisseur.
•Après chirurgie de membrane épirétinienne, l'épaisseur maculaire diminue mais le profil maculaire retourne rarement à la normale. Souvent, la surface rétinienne reste bombée avec un épaississement résiduel minime à modéré. Dans des cas plus favorables, s'ébauche de nouveau une dépression fovéolaire.

Sècheresse oculaire
•Symptômes
•La sècheresse oculaire provient d’une mauvaise qualité ou d’une diminution de la production de larmes et qui peut conduire à tout un faisceau de symptômes produisant un inconfort visuel tel que :
- •Des brûlures oculaires,
- •Des picotements
- •Sensation de grain de sable dans les yeux
- •Des yeux rouges
- •Vision floue par intermittence se normalisant par un clignement des paupières
- •Prurit, yeux collés le matin au réveil
- •Sensibilité à la lumière
- •Sensation de fatigue oculaire
•Un autre symptôme qui peut paraître antinomique pour le patient c’est le larmoiement excessif généré par l’œil sec et qui va déclencher un larmoiement réflexe avec une production excessive de larmes. Cet aspect peut se majorer à la lecture ou lors d’un travail sur écran offrant alors une endurance médiocre lors de cet exercice.
•Une instabilité du film lacrymal induit des aberrations optiques qui affectent la qualité de vision.
•Tous ces symptômes contribuent à altérer la qualité de vie des patients et peuvent affecter le psychisme de part son caractère chronique et invalidant.
•Les larmes :
Les larmes constituent la première interface entre le milieu extérieur et la cornée.
Elles hydratent, lubrifie et nettoient la surface de l’œil. Elle chasse la poussière et les micro-organismes qui peuvent agresser la surface de l’œil.
Elles sont produites de manière continue par les glandes lacrymales qui sont ensuite étalés sur la surface de l’œil grâce à la dynamique du clignement des paupières, assurant ainsi une lubrification constante.

•Les larmes sont constituées de 3 couches :
•la couche mucinique
•la couche aqueuse produite par la glande lacrymale
•la couche lipidique produite par les glandes de Meibomius
•On distingue la sécheresse oculaire en 2 entités :
- •La sècheresse liée à une hypo-sécrétion des larmes tel que dans les maladies inflammatoires chronique tel que la maladie Sjögren primaire ou secondaire ,polyarthrite rhumatoïde , dans les maladies de la glande lacrymale , anomalies de réflexe de larmoiement (paralysie faciale ou kératite neurotrophique)
- •La sècheresse liée à une hyper-évaporation des larmes en rapport avec des anomalies de la sécrétion lipidiques (Meibomite, Blépharite) et anomalies de la dynamique palpébrale (occlusion palpébrales partielles, déficit du clignements)
•L’association à d’autres pathologies doit être recherchée tel que la Rosacée, Dermite atopique ou des allergies.
•Les Glandes de Meibomius sont des glandes sébacées situées dans l’épiderme des paupières, plus précisément au niveau du tarse et qui sécrètent un corps gras appelé Meibum qui se mélange aux larmes et permet d’en retarder l’évaporation.
•Les clignements stimulent la sécrétion de ce meibum par les glandes de Meibomius quand elles rentrent en contact lors d’un clignement complet et étalent l’huile protectrice sur l’œil. En cas de clignement incomplet, les paupières ne se touchent plus et la pression exercée sur les glandes est insuffisante pour permettre une excrétion de cette huile qui finit par créer des bouchons par le durcissement du Meibum.

•La mauvaise qualité des larmes est dans la plupart des cas engendrée par un dysfonctionnement des glandes de Meibomius en présence d’une inflammation des paupières appel�� Blépharite.
Lorsque les glandes de Meibomius ne produisent suffisamment de Meibum, les larmes s’évaporent plus rapidement et produisent les différents symptômes décrit ci-dessus.
•Déficit du clignement et travail sur écran :
Le travail prolongé sur écran diminue la fréquence de clignement des paupières passant respectivement en moyenne de 10 à 12 clignements par minute à seulement 7 par minutes.
Cette diminution du clignement réduit la quantité du film lacrymal et entraine un inconfort visuel. Cette problématique sera également observée dans d’autres situations nécessitant une attention prolongée tel que la conduite ou la lecture.
-
•LE TRAITEMENT de la sècheresse par lumière pulsée EYELIGHT:
•Le traitement est articulé en 2 temps avec dans une premier temps l'application de lumière pulsée OPE qui dure environ 5 minutes puis dans un second temps l'application d'un masque dit LIGHT MODULATION qui dure environ 15 minutes
•OPE®: Il s’agit d’une lumière polychromatique, qui sous l’effet d’impulsions thermiques, stimule les glandes de Meibomius afin qu’elles puissent reprendre une activité normale. Appliquée sur les zones péri-orbitales et les pommettes, elle stimule la contraction des glandes afin d’améliorer la couche lipidique des larmes et ainsi réduire l’évaporation du film lacrymal.
•LIGHT MODULATION® est une technologie unique de photobiomodulation (PBM) utilisée depuis plusieurs années dans divers domaines de la médecine (dermatologie, dentaire, etc.). L'émission d'une lumière douce à une longueur d'onde déterminée déclenche une chaleur endogène des paupières. Ce traitement facilite l’écoulement du composant huileux des larmes - des glandes de Meibomius -, en stabilisant la couche lipidique du film lacrymal .
Glaucome
•Le glaucome est une maladie oculaire associé à une destruction progressive du nerf optique sous l’influence de plusieurs facteurs . L’un des facteurs les plus fréquent est l’hypertonie oculaire ou plus communément appelé l’hypertension intraoculaire, c’est à dire une pression trop importante à l’intérieur de l’œil induisant une compression mécanique de la tête du nerf optique à l’origine de la perte de fibres nerveuses.
L’atteinte fonctionnelle commence tout d’abord par la périphérie et compte tenu de son caractère asymptomatique, insidieux, le patient ne ressent une gêne que lorsque la vision centrale est atteinte. A ce stade très évolué, l’atteinte fonctionnelle est irréversible.
D’autre part, en plus de son caractère insidieux, le phénomène de complétion du cerveau joue le rôle de cache misère au début de la maladie, retardant alors le diagnostic.
L’enjeu repose donc sur un dépistage précoce de la maladie afin de préserver les cellules nerveuses .
•Facteurs de risque :
Certains facteurs peuvent accroitre le risque de glaucome tel que :
- Des antécédents familiaux de glaucome augmentent la prévalence de développer la maladie : 30% des glaucomes ont un caractère héréditaire .
- Une forte myopie
- Hypertension artérielle
- Diabète
- Une apnée du sommeil
- Prise prolongée de corticoïde
•Glaucome à Angle ouvert :
Cette hypertension intraoculaire est causée par un problème d’évacuation d’un liquide intraoculaire appelé l’humeur aqueuse qui s’évacue normalement au travers d’un filtre appelé trabéculum.

Dans le glaucome, la trabéculum entrave l’écoulement de l’humeur aqueuse et induit une augmentation de pression intraoculaire qui se répartissant dans tout le globe et plus spécifiquement sur le nerf optique détruisant progressivement les fibres nerveuses qui le constituent. Il s’agit de la forme la plus fréquente de la maladie .
•Traitement : Un traitement médical sous forme de collyre permet de normaliser la pression intraoculaire et de protéger les cellules nerveuses dans la majorité des cas . La maladie peut être contrôlée par une monothérapie dans plus de la moitié des cas . Parfois, plusieurs collyres peuvent être associées pour contrôler l’évolution de la maladie.
Le laser et/ou la chirurgie peuvent constituer une alternative intéressante en cas de mauvais contrôle de la maladie par le traitement médical seul.
•Glaucome à Angle fermé :
Dans le GFA, moins fréquent que le GAO, c’est l’anatomie de l’œil qui est altérée. En effet des particularités anatomiques associées ou non à une augmentation de l’épaisseur du cristallin dans l’œil participe à réduire l’angle irido-cornéen, siège du trabéculum, jusqu'à le fermer complètement, ce qui entrave le passage de l’humeur aqueuse. Un phénomène d’hypertension oculaire aigue alors se produit et on parle de glaucome par fermeture de l’angle.
Celui ci peut se manifester brutalement par des crises nocturnes , douloureuses et très destructives nécessitant un traitement en urgence .
Les crises sont parfois moins violentes, entrainant peu de douleurs mais détruisent le nerf optique de manière insidieuse, rapide et irréversible.

•Traitement : Compte tenu du caractère plus agressif de ce type de glaucome, il convient quand l’angle irido-cornéen présente une tendance à la fermeture de réaliser un traitement au laser préventif appelé iridotomie périphérique consistant à créer un petit trou dans l’iris en guise de « soupape de sécurité », afin de permettre une meilleur circulation de l’humeur aqueuse.
•Glaucome à Pression normale :
Plus rarement, le glaucome n’est pas en rapport avec une hypertension oculaire. On parle alors de glaucome à tension normale. Dans cette forme, on peut retrouver de composante vasculaires et/ou neurologiques qui aboutissent à des conséquences similaires aux autres formes de la maladie glaucomateuse.
Kératocône
Le kératocône correspond à une déformation de la cornée (le revêtement transparent de l’iris et de la pupille de l’oeil) qui s’amincit progressivement, perd sa forme sphérique normale et prend une forme de cône irrégulier. En effet, le mot kératocône, d’origine grecque, signifie «cornée conique». Cette déformation, survenant souvent vers la fin de l’adolescence, engendre des troubles de la vision (vue brouillée et déformée et mauvaise vision de loin) qui nécessitent le port de lentilles spécialisées. Le kératocône atteint généralement les deux yeux, mais pas avec la même sévérité. Le kératocône qui n'est pas contagieux est une pathologie oculaire non inflammatoire.
De nouvelles théories remettent en cause l'origine du Kératocône dont l'hyptohèse serait celle d'un syndrome d’origine mécanique primitivement causé par le frottement des yeux.
De nombreux patients atteints de kératocône présentent des signes d'allergies oculaires qui sont générateurs de nombreuses démangeaisons pouvant faire intervenir de nombreux frottement oculaires proportionnels à ces démangeaisons .
Les frottement itératifs sur la cornée induisent des déformations multiples du globe comme illustré sur la vidéo ci dessus du Dr Damien Gatinel , pionnier à avoir soutenu cette théorie, et seraient à l'origine de la déformation cornéenne .
Menu
- 1. La Cornée
- 2.L’iris
- 3.Cristallin
- 4.Le vitré
- 5. La rétine
- 6.Le nerf optique
- 1.MLA: Maculopathie Liée à l’âge( Stade prémice de la DMLA)
- 2.DMLA:Drusen Séreux
- 3.DMLA: Coalescence des Drusen et DEP Drusénoïde
- 4.Evolution de la DMLA
- A) DMLA Néovasculaire ou « Humide »
- B) DMLA Atrophique ou « sèche »
- Myopie forte
- Rétinopathie Diabétique
- Occlusion Vasculaire
- Maladie de Coats
- CRSC (Chorio-Rétinopathie -Séreuse-Centrale)
- Maladie de Best
- Rétinite Pigmentaire
- Décollement Postérieur du Vitré
- Traction Vitréo-Maculaire
- Déchirure Rétinienne à Clapet
- Décollement de Rétine
- Trou Maculaire
- Membrane Epirétinienne (M.E.R)
- Sècheresse oculaire
- Glaucome
- Kératocône
adresse
Centre Ophtalmologique Rabelais
2, Rue Antoine de Saint-Exupéry
69002 Lyon
04 78 95 09 08
Accès: Proche Bus/Métro
Lignes de métro : A et D
Bus : C20, C9, C10
Et 40 / 15 / 35
Prendre Rendez-vous:
Du Lundi au Jeudi de 9h à 18h
Et Le Vendredi de 9h à 17h00
